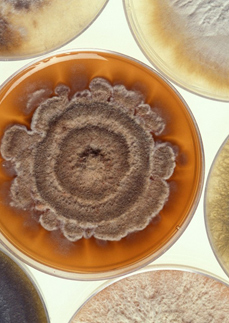

Laboratorní cvičení z mikrobiologie potravin II-a
Autoři
Ing. Zita Bastlová
Anotace
Výukový materiál bude sloužit jako návod do Laboratorního cvičení z mikrobiologie potravin a bude navazovat na teoretickou výuku. Studenti se podrobně seznámí s odběrem, přepravou a zpracováním vzorků pro mikrobiologické zkoušení. Osvojí si postup mikrobiologického rozboru potravinářských výrobků.
licence
Creative Commons BY-SA 4.0
Jazyk
česky
rok vzniku
2020
cena
ZDARMA
vzniklo za podpory